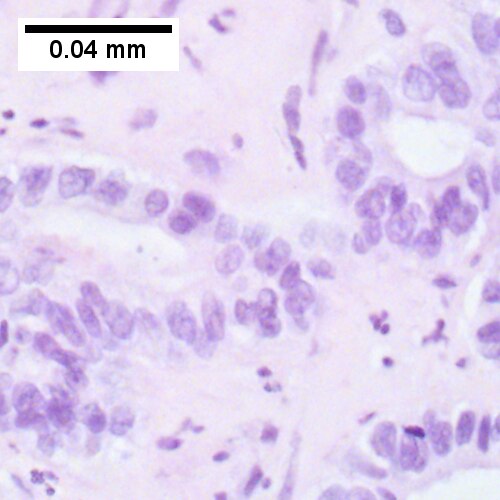
Cholangiocarcinoma, intrahepatic, large duct type.

Cholangiocarcinoma
| Cholangiocarcinoma | |
|---|---|
| Diagnosis in short | |
 Cholangiocarcinoma. H&E stain. | |
|
| |
| Synonyms | bile duct carcinoma |
|
| |
| LM | atypical cuboidal or columnar mucin producing cohesive cells (carcinoma) - usually gland forming (adenocarcinoma), classically with a dense fibrous (desmoplastic) stroma |
| LM DDx | metastatic carcinoma - esp. luminal GI tract, hepatocellular carcinoma |
| IHC | CK7 +ve, CK20 +ve/-ve, CK19 +ve, HepPar-1 -ve, AFP -ve, EMA +ve |
| Site | bile ducts (including pancreas, liver - see liver neoplasms) |
|
| |
| Associated Dx | liver flukes (Clonorchis sinensis, Opisthorchis viverrini), Caroli disease, primary sclerosing cholangitis - esp. in ulcerative colitis |
| Signs | +/-jaundice |
| Prevalence | uncommon |
| Blood work | +/-findings of cholestasis |
| Prognosis | poor |
| Clin. DDx | other liver tumours - hepatocellular carcinoma, metastases |
| Treatment | surgical resection if possible |
Cholangiocarcinoma is a malignant tumour that arise from the bile ducts and may been seen in the liver.
It is also known as bile duct carcinoma.[1]
General
- Malignancy of the biliary tree.
- May be intrahepatic, i.e. intrahepatic cholangiocarcinoma (abbreviated ICC), or extrahepatic.
Epidemiology
- Rare - approximately 1/5 the incidence of HCC.[2]
- More common among asians.
Risks:
- Infection - liver flukes (endemic to Southeast Asia):
- Caroli disease - rare congenital disease.[6]
- Primary sclerosing cholangitis - may be assoc. with inflammatory bowel disease (IBD), esp. ulcerative colitis (UC).
Gross
- Classically one large mass - outline described as cauliflower-like.[7]
- May have satellite nodules.
Image
Microscopic
Features:[8]
- Usually an adenocarcinoma, i.e. gland forming with:
- Cuboidal or columnar mucin producing cells, and
- A dense fibrous (desmoplastic) stroma.
Notes:
- Biliary stents lead to reactive changes,[9] these can be confused for malignancy. One must always check whether a biliary stent was in situ at time of biopsy.[10]
- Usually abundant desmoplasia, ergo hard to get good, i.e. diagnositic, endoluminal brushing specimens.[11]
- May have hyaline inclusions.[12]
DDx:
- Metastatic adenocarcinoma.
- Fulminant hepatic necrosis.
- Bile ducts usu. left behind... look like well-differentiated adenocarcinoma.
- Bile duct adenoma.
- No necrosis, no mitotic activity, no significant nuclear pleomorphism.
Images
Cholangiocarcinoma - low mag. Shows the typical desmoplastic stroma. (WC/Nephron)
Cholangiocarcinoma, intrahepatic, large duct type. Extremely unfortunate case arising in a pre-teenage girl. A. MRI showing multiple hepatic masses. B. A mass comprising often large ducts abuts uninvolved liver. C. CK7 immunostain emphasizes large, often adjoining ducts. D. Trichrome stain shows spread of tumor into scar with collagen deposition. E. Reticulin stain emphasizes disorderly vertical and horizontal spread of bizarrely shaped acini. F. PAS-D stain shows luminal mucin; note absence of red lining of outside of ducts seen in normal bile ducts/proliferating bile ductules. G. Loss of polarity (varied orientation with respect to base of epithelium) and variable size and shape of nuclei are obvious (Row 3 Right 400X, high pixel image).
Cholangiocarcinoma, intrahepatic, small duct type. Middle aged man with jaundice. A. Small dark tumorous masses [arrows] irrupt scar. B. Cribriforming (net like pattern) of gland in gland [arrow] without intervening stroma, which can be difficult to discern from reactive bile ducts at times. C. A second focus shows, on the left, glands with disorderly spread, further explored, and in the middle, partly formed glands with necrosis, further explored, both diagnostic. D. Note how some glands go up and down [red arrows] & others go right to left [black arrows] showing disorderly spread. E. Note necrotic cell nuclei [red arrows] and incompletely formed glands [black arrows]. F. Nuclear anaplasia is also able to be used for a definite diagnosis, but there is considerable nuclear variability in reactive bile duct proliferations, making it less facile than disorderly spread, incomplete glands, and necrotic nuclei.
Cholangiocarcinoma, intrahepatic, with associated abscess. A. Aberrant spaces (arrows) contrast with the scar to the regions left and, at right, hemosiderin laden macrophages amid granulation tissue . B. Disorderly spreading glands (black arrows) associated with atypical single cells (cyan arrows) have nuclei that contrast with those of the normal bile duct (blue arrow) with its associated artery (green arrow). C. PAS without diastase shows disorderly spreading, aberrantly shaped glands at left (arrows) and red degenerated hepatocytes to right. D. PAS with diastase shows proliferating bile ducts to left, one with highly aberrant nuclei (black arrow), highly atypical cells at middle (green arrows) with sometimes incomplete (cyan arrows) acini, and normal liver at right (blue arrow). E. CK7 immunostain shows proliferating glands at left and a disorderly spread of single cells and cell groups at right, amid hepatocytes. F. CK7 immunostain at higher power shows the stained cells have aberrant nuclei.
Cholangiocarcinnoma, intrahepatic, in a 72 year old man, poorly differentiated. A. Multiple cancerous foci strew otherwise unremarkable liver. B. Low cuboidal glands fuse and spread, with desmoplasia (green arrows points to slightly blue sttroma) and indian files (blue arrows). C. Aberrant single cells and cell clusters are present, with very little apparent cytoplasm, with extremely variable nuclei, with black and sometimes bubbly chromatin. Note close approximation raising possibility of molding (arrows). D. A mucicarmine stain, even when negative, can highlight the epithelial grouping of the nuclei by virtue of the slightly pink stroma. E. CK7 immunostain shows mostly groups, but also demarcates isolated cancer cells amid scar. Tumor was negative for p40, CK20 CDX2, TTF1, PAX8.
www:
- Cholangiocarcinoma & liver flukes - several images (upmc.edu).
- Cholangiocarcinoma - several images (upmc.edu).
IHC
Classic IHC pattern:[13]
Others:
Note:
- MUC-1 is also known as EMA.
Hepatocellular carcinoma versus cholangiocarcinoma
ICC vs. HCC:[15]
HCC vs. ICC:[16]
- TTF-1: ~90-100% +ve (cytoplasmic) in HCC vs. ~10% in cholangiocarcinoma.
Molecular
- Approx. 10% of the tumors carry a IDH-1 or IDH-2 hotspot mutation.[17]
- FGFR2 gene fusions have been reported.[18]
Sign out
MASS, PANCREAS, CORE BIOPSY: - ADENOCARCINOMA, MODERATELY DIFFERENTIATED.
Note:
- On biopsy, it isn't possible to cleanly separate from pancreatic adenocarcinoma. Thus, it is better to stay vague.
Alternate
Liver, Core Biopsy: - ADENOCARCINOMA, see comment. Comment: The tumour stains as follows: POSITIVE: CK7 (strong, diffuse), CK19 (moderate, diffuse), HNF1b (moderate, diffuse). NEGATIVE: CK20, GATA3, HepPar-1, PAX-8, WT-1, CDX2, mammaglobin, TTF-1. The findings would be compatible with a foregut primary lesion; a non-exhaustive list of possibilities includes: cholangiocarcinoma, pancreatic adenocarcinoma and gastric adenocarcinoma. Clinical and radiologic correlation is required.
Micro
The sections show an atypical gland-forming lesion (adenocarcinoma) in a fibrous background. This lesion is separate from the benign pancreatic glands that are present. The atypical glands are unequally spaced. Moderate-to-marked cytologic atypia is present. Mitotic activity is not readily apparent.
See also
References
- ↑ URL: http://www.cancer.org/cancer/bileductcancer/detailedguide/bile-duct-cancer-what-is-bile-duct-cancer. Access on: 23 May 2013.
- ↑ Iacobuzio-Donahue, Christine A.; Montgomery, Elizabeth A. (2005). Gastrointestinal and Liver Pathology: A Volume in the Foundations in Diagnostic Pathology Series (1st ed.). Churchill Livingstone. pp. 608. ISBN 978-0443066573.
- ↑ Cotran, Ramzi S.; Kumar, Vinay; Fausto, Nelson; Nelso Fausto; Robbins, Stanley L.; Abbas, Abul K. (2005). Robbins and Cotran pathologic basis of disease (7th ed.). St. Louis, Mo: Elsevier Saunders. pp. 926. ISBN 0-7216-0187-1.
- ↑ Park, do H.; Son, HY. (Apr 2008). "Images in clinical medicine. Clonorchis sinensis.". N Engl J Med 358 (16): e18. doi:10.1056/NEJMicm054461. PMID 18420495.
- ↑ de Martel C, Plummer M, Franceschi S (March 2010). "Cholangiocarcinoma: Descriptive epidemiology and risk factors". Gastroenterol Clin Biol. doi:10.1016/j.gcb.2010.01.008. PMID 20202771.
- ↑ Ananthakrishnan AN, Saeian K (April 2007). "Caroli's disease: identification and treatment strategy". Curr Gastroenterol Rep 9 (2): 151–5. PMID 17418061.
- ↑ Nakanishi, Y.; Zen, Y.; Kawakami, H.; Kubota, K.; Itoh, T.; Hirano, S.; Tanaka, E.; Nakanuma, Y. et al. (Jul 2008). "Extrahepatic bile duct carcinoma with extensive intraepithelial spread: a clinicopathological study of 21 cases.". Mod Pathol 21 (7): 807-16. doi:10.1038/modpathol.2008.65. PMID 18425077.
- ↑ Iacobuzio-Donahue, Christine A.; Montgomery, Elizabeth A. (2005). Gastrointestinal and Liver Pathology: A Volume in the Foundations in Diagnostic Pathology Series (1st ed.). Churchill Livingstone. pp. 609. ISBN 978-0443066573.
- ↑ Carrasco, CH; Wallace, S; Charnsangavej, C; Richli, W; Wright, KC; Fanning, T; Gianturco, C (Dec 1985). "Expandable biliary endoprosthesis: an experimental study.". AJR Am J Roentgenol 145 (6): 1279-81. PMID 3877438.
- ↑ STC. 2 October 2009.
- ↑ 11.0 11.1 STC. 6 December 2010.
- ↑ Aishima, S.; Fujita, N.; Mano, Y.; Iguchi, T.; Taketomi, A.; Maehara, Y.; Oda, Y.; Tsuneyoshi, M. (Sep 2010). "p62+ Hyaline inclusions in intrahepatic cholangiocarcinoma associated with viral hepatitis or alcoholic liver disease.". Am J Clin Pathol 134 (3): 457-65. doi:10.1309/AJCP53YVVJCNDZIR. PMID 20716803.
- ↑ Iacobuzio-Donahue, Christine A.; Montgomery, Elizabeth A. (2005). Gastrointestinal and Liver Pathology: A Volume in the Foundations in Diagnostic Pathology Series (1st ed.). Churchill Livingstone. pp. 609. ISBN 978-0443066573.
- ↑ Higashi, M.; Yamada, N.; Yokoyama, S.; Kitamoto, S.; Tabata, K.; Koriyama, C.; Batra, SK.; Yonezawa, S. (2012). "Pathobiological implications of MUC16/CA125 expression in intrahepatic cholangiocarcinoma-mass forming type.". Pathobiology 79 (2): 101-6. doi:10.1159/000335164. PMID 22286058.
- ↑ [Evaluation of immunohistochemical markers for differential diagnosis of hepatocellular carcinoma from intrahepatic cholangiocarcinoma] Dong H, Cong WL, Zhu ZZ, Wang B, Xian ZH, Yu H. Zhonghua Zhong Liu Za Zhi. 2008 Sep;30(9):702-5. Chinese. PMID 19173916.
- ↑ Lei JY, Bourne PA, diSant'Agnese PA, Huang J (April 2006). "Cytoplasmic staining of TTF-1 in the differential diagnosis of hepatocellular carcinoma vs cholangiocarcinoma and metastatic carcinoma of the liver". Am. J. Clin. Pathol. 125 (4): 519–25. doi:10.1309/59TN-EFAL-UL5W-J94M. PMID 16627262.
- ↑ Wang, P.; Dong, Q.; Zhang, C.; Kuan, PF.; Liu, Y.; Jeck, WR.; Andersen, JB.; Jiang, W. et al. (Jun 2013). "Mutations in isocitrate dehydrogenase 1 and 2 occur frequently in intrahepatic cholangiocarcinomas and share hypermethylation targets with glioblastomas.". Oncogene 32 (25): 3091-100. doi:10.1038/onc.2012.315. PMID 22824796.
- ↑ Wu, YM.; Su, F.; Kalyana-Sundaram, S.; Khazanov, N.; Ateeq, B.; Cao, X.; Lonigro, RJ.; Vats, P. et al. (Jun 2013). "Identification of targetable FGFR gene fusions in diverse cancers.". Cancer Discov 3 (6): 636-47. doi:10.1158/2159-8290.CD-13-0050. PMID 23558953.